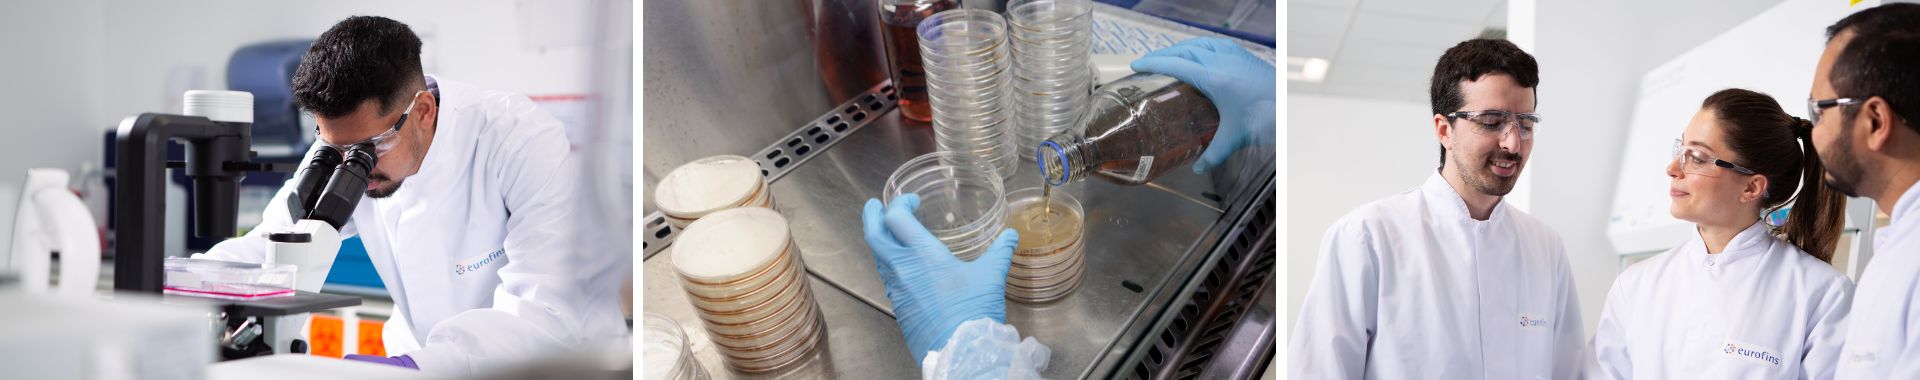
Production souches calibrees Eurofins BPT France

Recherche >>
Production de souches calibrées
Contactez-nous
Dans le cadre de la maitrise de la contamination, l’utilisation de souches de micro-organismes est requise pour différents contrôles et différentes validation (fertilité des milieux de culture, applicabilité des méthodes, validation de désinfectants, etc…).
Pour cela, le réseau de sociétés d'Eurofins BioPharma Product Testing France propose une production maitrisée et une quantification adaptée d’inoculum variés.
Productions à façon
- Bactéries (dont mycoplasmes), levures, moisissures.
- Souches de référence, souches « usine/environnementale », souches industrielles ou de R&D
- Concentration à façon, calibration précise (de <100 UFC à 10E9 UFC)
- Format congelé ou culture fraiche
- Stockage à <-70°C, <-130°C ou +5°C - En savoir plus sur la conservation
- Certificat fourni avec chaque banque produite
- Sécurisation de vos souches et suivi de leur stabilité et viabilité.
Exemples d'application
- Vous êtes un laboratoire de R&D et/ou de production
- Production de Master Cell Bank, Research Cell Bank et Working Cell Bank
- Criblage de souches pour les travaux de recherche et développement
- Utilisation de souches pour validation d’efficacité thérapeutique
- Archivage de microorganismes issus de prélèvements industriels
- Vous êtes un laboratoire de contrôle qualité
- Production de lots et d’inoculum calibrés pour les tests de fertilité des milieux de culture
- Production de lots et d’inoculum calibrés pour les validations de méthodes
- Production de lots et d’inoculum calibrés pour les validations de l’efficacité de désinfectants
- Test d’efficacité de la conservation antimicrobienne avec vos souches sauvages
- Etc.
Nous contacter
Si vous souhaitez travailler avec Eurofins sur un projet BioPharma, remplissez le formulaire de contact, nos équipes vous contacteront dans les meilleurs délais.
Merci pour votre demande